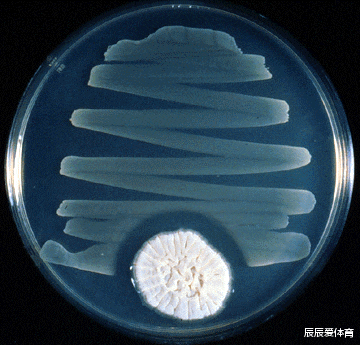
「基因」这位研究生周末偷个懒，却意外破解了啤酒的千古之谜

「基因」这位研究生周末偷个懒,却意外破解了啤酒的千古之谜
文章图片

文章图片

文章图片
青霉素发现的故事想必大家不陌生吧?英国的弗莱明爵士 , 做实验的时候污染了一丁点霉菌 。 后来发现飘落霉菌的地方 , 病原菌寸草不生 , 才意识到产黄青霉分泌的青霉素 , 具有杀灭细菌的作用 。 这一伟大发现 , 拯救了数以亿计的人类 , 被评为历史上最伟大的发明之一 。
林哥今天不聊抗生素 , 那就扯远了 。 用这个故事做开头的原因是 , 这种彩票中头奖一样的运气 , 被一位比利时啤酒科学家碰上了 , 让我们隆重介绍一下故事的主角 , 来自比利时鲁汶大学的遗传学家Kevin Verstrepen 。 在那段时间Verstrepen一直在忙于折腾 , 酿酒酵母里的ATF1基因 。
生物学家Kevin Verstrepen , 长得还挺精神
实验室事情很多 , Verstrepen还特意嘱咐学生 , 别偷懒 , 周末之前搞搞实验室卫生 , 不要又是一团糟 。 啤酒实验室 , 原料都是高营养 , 招来老鼠、蟑螂就麻烦了 。 就算是苍蝇蚊子也受不了呀 。
培养皿盖子还忘了盖 。 杯具还是洗具呢?
新来的研究生Luis , 毛头小子一个 , 手里照看了两种酿造啤酒的微生物 。 “普通的酿酒酵母”和“atf1被敲除的菌株” , 平板忘了盖盖子 , 丢在桌子上 。 屋漏偏逢连阴雨 , 隔壁实验养果蝇的小箱子也忘了密封 。 周一 , Verstrepen早上巡视实验室 , 我的天简直一锅粥 。 正要发火 , 咦?奇迹的事情发生了:是否含有atf1基因 , 竟然在吸引果蝇的能力上大相径庭 。
普通酿酒酵母吸引大量果蝇 , 缺失atf1基因不再吸引果蝇
酿酒酵母上一段基因的变化 , 导致啤酒香味出现了巨大的差异 , 以至于连果蝇都不来了 , 真的成了名副其实的“狗不理” 。 经过Verstrepen课题组的后续分析 , 很快真相大白 , atf1负责调解酿酒酵母的酒精乙酰酯化酶活性 , 缺了这种基因 , 和啤酒香气(Aroma)有关的一系列化合物都合成不出来了(包括乙酸乙酯 , 乙酸异戊酯 , 乙酸苯乙酯等等等) 。 而果蝇的嗅叶有这些酯类的感受器 , 啤酒不香了 , 当然就不光顾了 。
这真是:
啤酒香不香?
果蝇最知道 。
要想啤酒稥 ,
基因上鼓捣 。
“啥 , 科学就这么简单?十年前老子就想到用啤酒瓶里的剩啤酒吸引苍蝇了 , 没想到还有这么深刻的科学道理 , 原来老子本来也是当科学家的料呀 。 ” 林哥要说 , 这里面意义还是很大的 。
南美之角 , 巴塔哥尼亚的虫瘿 , 野生酵母的甜蜜小屋
还用之前聊过的 , 巴塔哥尼亚的山毛榉树林 , 虫瘿中的酵母为例 。 想想看 , 酵母占领一个虫瘿果 , 生存下来没什么问题 。 可是 , 果子里的糖水被吃完时 , 酵母本身又没有翅膀 , 如果不能让子孙后代的找到新的根据地 , 酵母还是难逃灭绝的悲剧 。 怎么办?酵母的策略是:拼命制造有香味的气息 , 吸引果蝇 。 果蝇闻着香味 , 过来分享酵母劳动果实的同时 , 脚上会沾染一些酵母的细胞 , 就会顺便帮助酵母完成迁徙 。 这故事是不是很酷呀?其实在人类学会利用酵母发酵出香甜饮料之前的漫长历史长河中(数百万 , 甚至数千万年的时间) , 大自然就是通过这种方式 , 通过自然选择 , 已经筛选出了最能产生香味的酵母 , 真的是太神奇了 。
还不止这些呢 , 酵母里的基因开关 , 还能帮助调节啤酒的酒精度 , 降低硫化物臭味 , 增加果香味 , 增加酯香气 , 等等等等太多了
推荐阅读
- DeepTech深科技@下一次流行病暴发,能否利刃出鞘?,“基因魔剪”对抗新冠现锋芒
- #读创网#下潜到4000米深的海底是什么体验?清华大学深圳国际研究生院专家带你深海探险
- 昊明有态度:孔凡江/刘宝辉团队报道作物驯化过程中开花期基因的进化与选择分子机制
- 上品课堂■孔凡江刘宝辉团队报道作物驯化过程中开花期基因的进化与选择
- 「同花顺财经」全新AutoML工具实现基因组全自动建模“宝藏技术”解读生命天书
- #科技泰坦#Ace家族基因,携90Hz直屏震撼来袭!网友华为别慌,Ace2或继承Reno
- 『基因』健康人要做基因检测吗?符合4种情况最好做,哪怕为了孩子
- 【基因】超能力?基因变化后的特殊能力,只有极少数人类拥有
- 『盲菓说』这位中国富豪你怎么看?,刚给美国捐款7000万,就被起诉宣布破产
- #秋裤#为什么只有中国人穿秋裤?是我们丧失“抗寒基因”了吗
